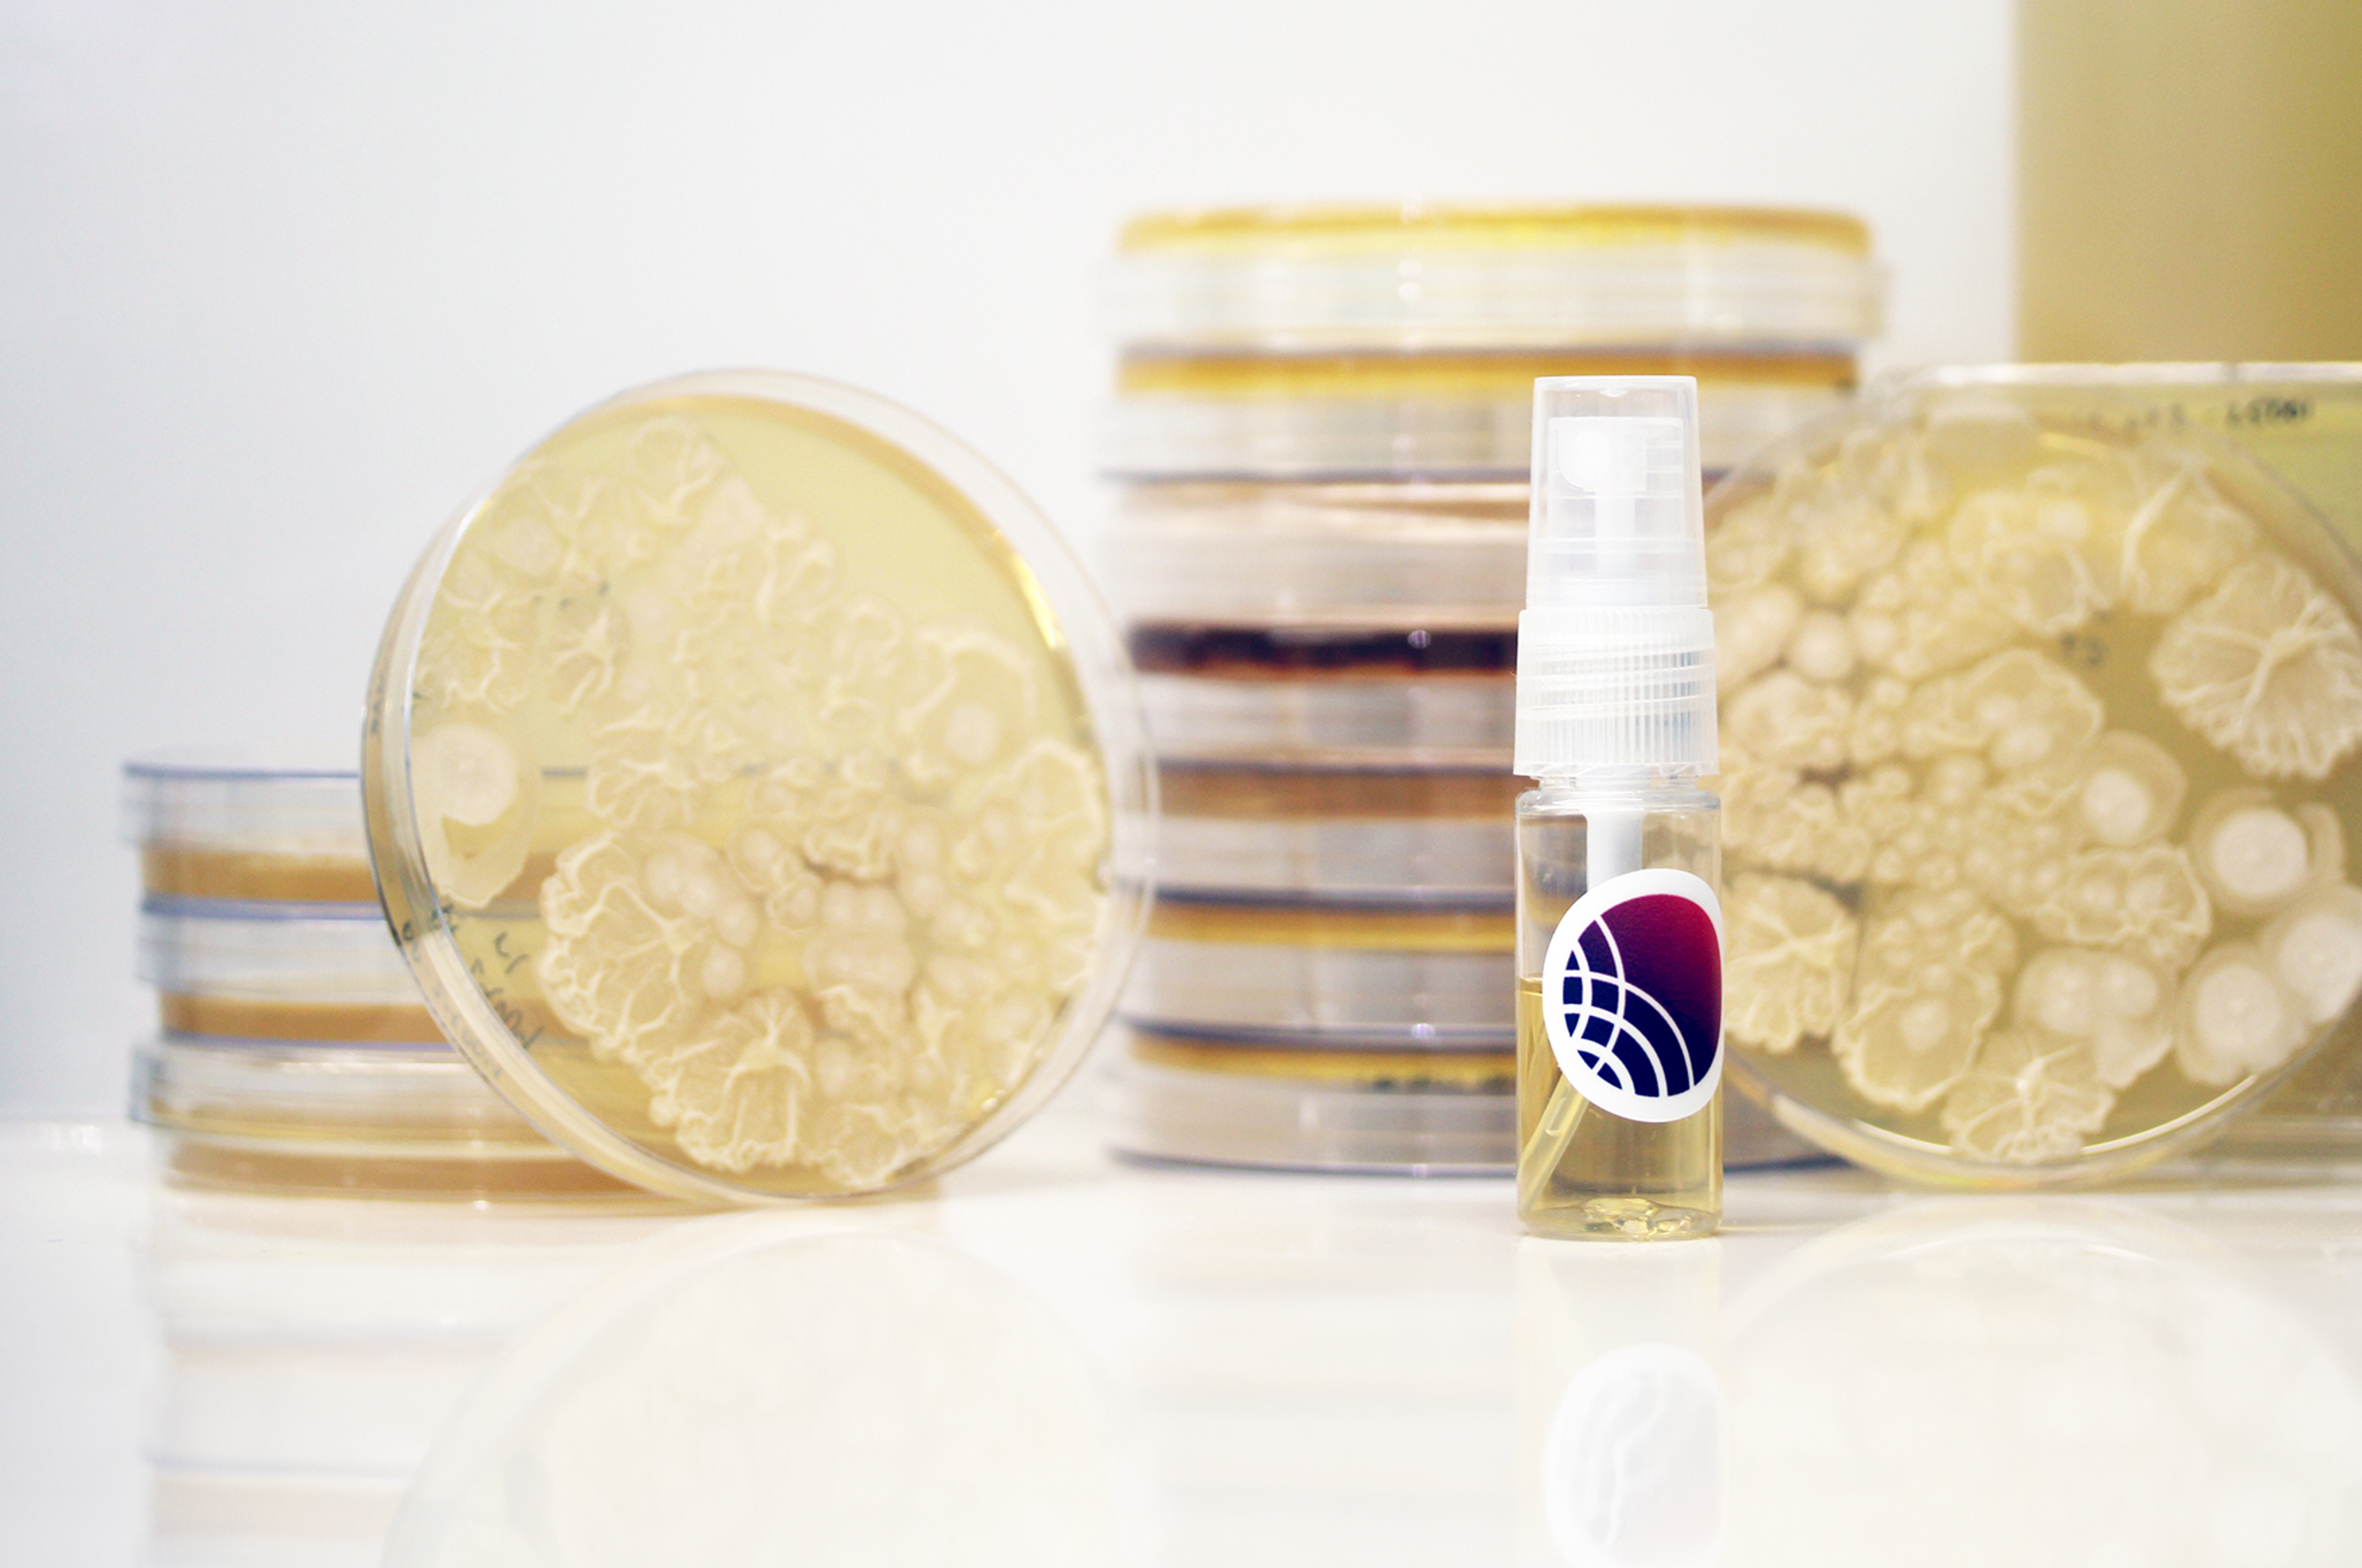

Discovered through ultra-high-throughput microbial screening, our ingredients deliver science-first solutions across skin health needs.

Consumer skincare relies on decades-old ingredients, leading to disengaged consumers and poorly differentiated brands. Consumers and leading brand builders want innovation.
New, differentiated ingredients aren’t just a competitive edge—they’re the future of skin, scalp, and body care.

Half of U.S. consumers seek microbiome-friendly skincare. Microbial ferments offer a natural source of differentiated, science-driven ingredients for the future of skincare.
Our ingredient portfolio transforms microbial ecology into differentiated solutions for consumers, spanning deodorant, barrier support, dandruff, and acne care.
ENS-002 pacifies S. aureus virulence as a candidate therapeutic for atopic dermatitis—now in development at Fermata Dermatologics.
Learn more at fermatadermatologics.com
ENS-003 inhibits C. albicans virulence—seeding Concerto’s understanding of how the vaginal microbiome maintains a healthy balance.
Learn More About ENS-003
Concerto’s partners gain access to top-performing, differentiated ingredients that add value to their portfolios. Inquire about the list of ingredient candidates we have waiting in the wings. Or propose a new product concept that leverages Concerto’s 50+ million data points across skin and vaginal health.

750 Main Street
Cambridge, MA 02139